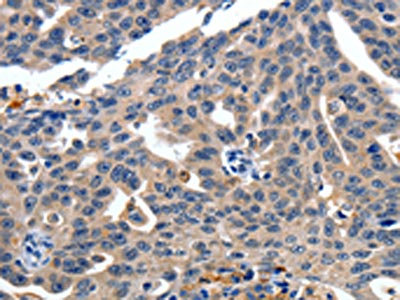
CSB-PA782639

ITGAX
ITGAX,全稱為整合素αX鏈蛋白,常見別名包括CD11c和補體成分3受體4亞基。該蛋白是白細胞特異性整合素的重要組成部分,與β2鏈(ITGB2)結合形成復合物,參與細胞粘附、遷移和信號傳導等過程。ITGAX蛋白在免疫細胞中發揮關鍵作用,尤其是在樹突狀細胞、單核細胞和巨噬細胞中高表達。它參與多種免疫反應,包括炎癥反應、抗原呈遞和免疫調節。ITGAX蛋白還與某些疾病的發生發展密切相關,如癌癥、自身免疫性疾病和感染性疾病。在藥物研發方面,針對ITGAX蛋白的抗體藥物和抑制劑已被開發用于治療癌癥和炎癥性疾病。例如,抗ITGAX抗體可用于阻斷腫瘤細胞的粘附和轉移,而ITGAX抑制劑則可減輕炎癥反應。目前,ITGAX蛋白相關的研究仍在不斷深入,未來有望為更多疾病的治療提供新的策略。
熱銷產品
驗證數據

The image on the left is immunohistochemistry of paraffin-embedded Human liver cancer tissue using CSB-PA782639(ITGAX Antibody) at dilution 1/15, on the right is treated with synthetic peptide. (Original magnification: ×200)
The image on the left is immunohistochemistry of paraffin-embedded Human ovarian cancer tissue using CSB-PA782639(ITGAX Antibody) at dilution 1/15, on the right is treated with synthetic peptide. (Original magnification: ×200)
ITGAX Antibody (CSB-PA011879ESR1HU)
驗證數據

Western blot
All lanes: ITGAXantibody IgG at 1.59μg/ml + Mouse kidney tissue
Secondary
Goat polyclonal to rabbit IgG at 1/10000 dilution
Predicted band size: 128 kDa
Observed band size: 128 kDa

Immunohistochemistry of paraffin-embedded human tonsil tissue using CSB-PA011879ESR1HU at dilution of 1:100

Immunohistochemistry of paraffin-embedded human lung cancer using CSB-PA011879ESR1HU at dilution of 1:100

Immunofluorescent analysis of Hela cells using CSB-PA011879ESR1HU at dilution of 1: 100 and Alexa Fluor 488-congugated AffiniPure Goat Anti-Rabbit IgG(H+L)
ITGAX Antibodies
ITGAX for Homo sapiens (Human)
| 產品貨號 | 產品名稱 | 種屬反應性 | 應用類型 |
|---|---|---|---|
| CSB-PA011879GA01HU | ITGAX Antibody | Human,Mouse | ELISA,WB,IHC |
| CSB-PA091944 | ITGAX Antibody | Human | ELISA,WB |
| CSB-PA843535 | ITGAX Antibody | Human | ELISA,IHC |
| CSB-PA782639 | ITGAX Antibody | Human | ELISA,IHC |
| CSB-PA011879ESR1HU | ITGAX Antibody | Human, Mouse | ELISA, WB, IHC, IF |
ITGAX Proteins
ITGAX Proteins for Homo sapiens (Human)
| 產品貨號 | 產品名稱 | 來源 |
|---|---|---|
| CSB-YP011879HU CSB-EP011879HU CSB-BP011879HU CSB-MP011879HU CSB-EP011879HU-B |
Recombinant Human Integrin alpha-X (ITGAX), partial | Yeast E.coli Baculovirus Mammalian cell In Vivo Biotinylation in E.coli |
ITGAX Proteins for Mus musculus (Mouse)
| 產品貨號 | 產品名稱 | 來源 |
|---|---|---|
| CSB-YP874106MO CSB-EP874106MO CSB-BP874106MO CSB-MP874106MO CSB-EP874106MO-B |
Recombinant Mouse Integrin alpha-X (Itgax), partial | Yeast E.coli Baculovirus Mammalian cell In Vivo Biotinylation in E.coli |
| CSB-BP874106MO1 | Recombinant Mouse Integrin alpha-X (Itgax), partial | Baculovirus |














